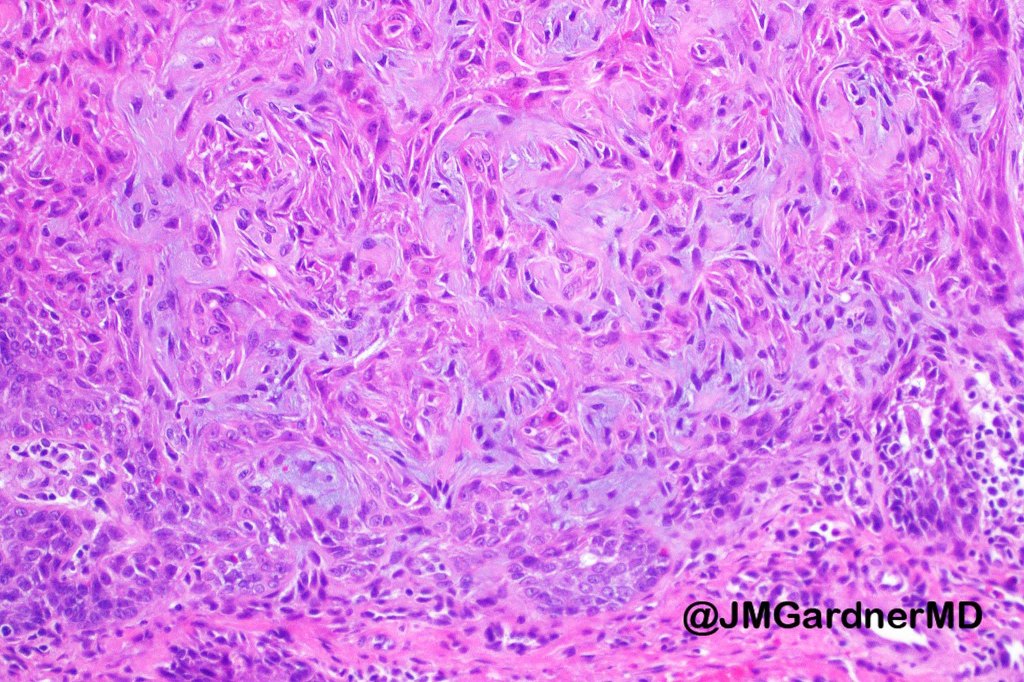
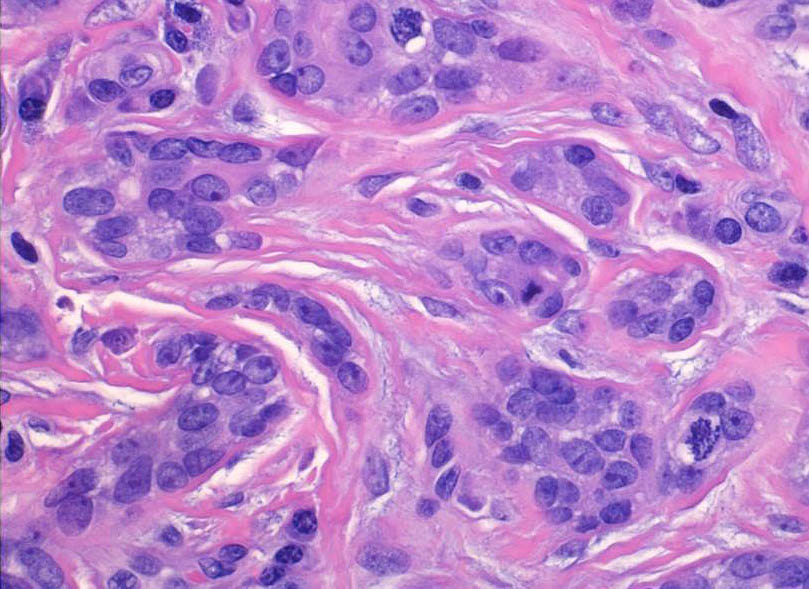

Clinical features
•Generally, presents in childhood as a solitary gray/brown warty lesion on the scalp with a moist surface
•Can arise at other sies including face, neck, trunk & legs and elsewhere
•Can be present at birth
•A common tumor in a background of nevus sebaceus
•Rarely linear lesion
•Segmental following lines of Blaschko
•May arise in association with benign apocrine cysts & sweat gland tumors
Histological features
•Scanning magnification shows an exophytic tumor or an epidermal invagination enclosing epithelial covered papillae with a fibrovascular core
•Glands are present at the base of the lesion
•At the edges, the squamous epithelium is in continuity with the glandular one
•The epithelium consists of outer myoepithelial cells supporting an inner layer of columnar cells with abundant eosinophilic cytoplasm showing decapitation secretion
•Dense plasma cell infiltrate
•The base of the lesion may merge with an apocrine tubular adenoma
•AE1/AE3, CAM 5.2, EMA & CEA +ve
•Variable GCDFP-15 & HMFG +ve
•Maligant change- syringocystadenocarcinoma papilliferum is exceptionally rare & is characterised by nuclear pleomorphism, excessive mitotic activity, abnormal mitoses; most cases appear to be clinically low grade

Leave a comment